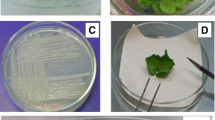

Abstract
Salvia miltiorrhiza Bunge (Lamiaceae) hairy root cultures were inoculated (at 0.02 and 0.2% v/v) and co-cultured with Bacillus cereus bacteria. The root biomass growth was inhibited significantly by the bacteria inoculated to the root culture on the first day (day 0) but not by the bacteria inoculated on days 14 or 21 (in a 28-day overall period). On the other hand, the growth of the bacteria in the hairy root culture was also strongly inhibited by the hairy roots, partially because of the antibacterial activity of the secondary compounds produced by the roots. Most interestingly, the tanshinone production was promoted by the inoculation of bacteria at any of these days but more significantly by an earlier bacteria inoculation. With 0.2% bacteria inoculated on day 0, for example, the total tanshinone content of roots was increased by more than 12-fold (from 0.20 to 2.67 mg g−1 dry weight), and the volumetric tanshinone yield increased by more than sixfold (from 1.40 to 10.4 mg l−1). The tanshinone production was also stimulated by bacterial water extract and bacterial culture supernatant but less significantly than by the inoculation of live bacteria. The results suggest that the stimulation of tanshinone production by live bacteria in the root cultures may be attributed to the elicitor compounds originating from the bacteria, and the hairy root–bacteria coculture may be an effective strategy for improving secondary metabolite production in plant tissue cultures.
Similar content being viewed by others
Explore related subjects
Discover the latest articles, news and stories from top researchers in related subjects.Avoid common mistakes on your manuscript.
Introduction
Plants synthesize a diverse array of secondary metabolites that are important for them to survive and flourish in the natural environment. The secondary metabolites play an important role in plant–microbe interactions, particularly in the plants’ defenses against pathogenic attacks. On the other hand, secondary metabolites in plants represent a major source of bioactive natural products as valuable pharmaceuticals and nutraceuticals. Plant tissue cultures (including cell and organ cultures) are useful experimental models for the study of plant stress physiology and secondary metabolism and efficient bioprocesses for the mass production of valuable secondary metabolites, particularly from those rare and slow-growing plant species.
Hairy roots are plant roots transformed by the infection of wounded plant tissues with Agrobacterium rhizogenes. Because of the rapid hormone-free growth and high genetic stability of hairy roots, hairy root culture is a convenient tool for plant science research and a promising production system for medicinal plants and their active constituents (Giri and Narasu 2000; Guillon et al. 2006). Salvia miltiorrhiza Bunge (Lamiaceae) is a well-known herbal plant and its root, which is known as Danshen in Chinese, has been widely used in Chinese medicine for the treatment of menstrual disorders and cardiovascular diseases and for the prevention of inflammation (Tang and Eisenbrand 1992; Wang et al. 2007). The diterpenoid pigments, which are generally known as tanshinones, are the major bioactive constituents of S. miltiorrhiza roots. Hairy root cultures of S. miltiorrhiza have been established as a potential means for the production of tanshinones and other bioactive compounds (Hu and Alfermann 1993; Chen et al. 1999).
As the accumulation of many secondary metabolites in plants is a defense response of the plants to microbial pathogens, microbial components such as cell wall fragments of fungi and bacteria can be used as elicitors to induce and stimulate the production of secondary metabolites in plant tissue cultures (Rao and Ravishankar 2002; Zhao et al. 2005). For example, a carbohydrate fraction of yeast extract has been used effectively to stimulate tanshinone production in S. miltiorrhiza hairy root cultures (Chen et al. 2001; Ge and Wu 2005). To the best of our knowledge, however, there is still no reported work on the use of live microbial cells to stimulate secondary metabolite production in plant tissue cultures. In routine laboratory practice of plant tissue cultures, the presence of microbial cells in culture is regarded as contamination, which would strongly inhibit or completely stop the growth of plant tissue or cells. In most previous studies on plant responses to pathogens, live microbial cells have been mainly applied to the tissue of living plants (in vivo), and microbial cell fragments or compounds have been applied to plant tissue and cell cultures (in vitro), to induce the responses for investigation (Ebel and Cosio 1994; Zhao et al. 2005). Nevertheless, a few groups have directly inoculated live bacteria to plant cell cultures, such as the zoospores of Phytophthora nicotianae (Able et al. 2001, 2003) and a mutant strain of Pseudomonas syringae (Keppler et al. 1989; Atkinson et al. 1985, 1990) to tobacco cells in suspension cultures, to induce and study the pathogenic responses of plants. In these studies, these live bacteria cells were as effective as the crude fractions or purified compounds of microbial cells to induce or elicit defense responses such as hypersensitive reaction, membrane cation ion fluxes (Ca2+, K+, and H+), and production of reactive oxygen species (ROS).
Plant defense mechanisms can also be stimulated by beneficial and growth-promoting microorganisms, especially the rhizobacteria that colonize the roots of plants. Bacillus cereus is one of the most common rhizobacterial species that have been shown to enhance plant resistance to bacterial and fungal pathogens (Kloepper et al. 2004; Barea et al. 2005). As an initiative to explore a novel and effective means for enhancing the secondary metabolite production in plant hairy root cultures, this study was to examine the growth and secondary metabolite production of S. miltiorrhiza hairy roots during the coculture with a bacterium B. cereus, as well as the influence of hairy roots on bacteria growth.
Materials and methods
Hairy root culture
The S. miltiorrhiza hairy root culture was derived after the infection of plantlets with a Ri T-DNA-bearing A. rhizogenes bacterium (ATCC15834; Chen et al. 1999). The stock culture of the hairy roots was maintained on a solid, hormone-free MS medium (Murashige and Skoog 1962) with 8 g l−1 agar, 30 g l−1 sucrose, and 0.5 g l−1 casein hydrolysate but without ammonium nitrate, at 25°C in the dark. Experiments in this study were all performed in shake-flask cultures in a liquid medium of the same composition as of the solid culture but excluding the agar as described previously (Ge and Wu 2005). Each flask (125-ml Erlenmeyer) was filled with 25 ml medium and inoculated with 0.2 g fresh roots from 3-week-old shake-flask cultures. The shake-flask hairy root culture was run for an overall period of 28 days, during which some flasks were taken out at selected days for measurement. All treatments were performed in triplicate and repeated at least once, and the results were averaged.
Measurement of root weight and residual sucrose and total nitrogen in medium
The hairy roots were picked out from the liquid medium with a pair of forceps, rinsed thoroughly with distilled water, and then blotted dry by paper towels (yielding the fresh weight), and then dried at 45–50°C in an oven until constant dry weight (dw). The liquid medium was collected for the measurement of residual nutrients (sucrose and total nitrogen), pH, and conductivity. Sucrose content in the liquid medium was determined by the Anthrone method using sucrose as a standard (Ebell 1969). Total nitrogen was determined by the standard Kjeldahl method (ASTM3590, 2002) using NH4Cl as a reference and expressed as the total Kjeldahl nitrogen. The medium pH and conductivity were measured with the respective electrodes.
Bacterial culture and inoculation into hairy root culture
The B. cereus bacterium (Gram-positive) was taken from our departmental microbial culture storage. During this study, the bacterial culture was maintained on a solid Luria–Bertani (LB) medium with 15 g l−1 agar at 4°C. The bacteria inocula for the root–bacteria coculture experiments were prepared by growing the bacteria in liquid LB medium (pH 7.0) at 30°C in shake flasks at 250 rpm for 2 h, reaching a maximum optical density (OD) value of 0.5 (pH 6.5). The culture broth was inoculated into the hairy root culture in shake flasks at 0.02 and 0.2% (v/v; 5–50 μl broth in 25 ml medium) on days 0, 14, or 21 of the hairy root culture. Bacteria cell density in the LB medium and the MS medium was evaluated by the OD measured at 600 nm with a spectrophotometer.
In addition to live bacteria, bacterial extract and bacterial culture supernatant (used medium) were also tested of their effects on the hairy root growth and tanshinone production. For preparation of the bacterial extract, bacterial cells were harvested from the B. cereus culture in the LB medium (after 2 h incubation) by filtration. The cell mass was resuspended in distilled water (5 g in 100 ml) and autoclaved at 121°C for 20 min. The autoclaved cell suspension was centrifuged at 6,000 rpm for 5 min, and the supernatant was collected as the bacterial extract. The concentration of the bacterial extract was represented by the total carbohydrate content, which was determined by the Anthrone test using glucose as a standard. In this study, a fixed concentration 100 μg ml−1 of bacterial extract was chosen based on our previous studies using the carbohydrate fraction of yeast extract as an elicitor in the hairy root culture (Ge and Wu 2005). The bacterial extract was fed to the root cultures on day 0 or 21.
The bacterial culture supernatant for the test was collected from the B. cereus bacterial culture in the MS medium with or without the hairy roots in the culture at various days (days 1, 7, 21) of the culture period. The hairy root culture medium without the bacteria was also collected (on day 21) and tested for comparison. The bacteria- and root-free culture supernatants were obtained by filtration of the culture broth and then sterilized by filtration through a 0.2-μm membrane. In all experiments, 5 ml of the sterile bacterial or root culture supernatant was mixed with 20 ml fresh MS medium on the first day (day 0) of the root culture in each culture flask.
Analysis of tanshinones in roots
The extraction and analysis of tanshinones from the roots followed the procedures as described by Ge and Wu (2005). In brief, the dried hairy roots were ground into powder and extracted with 4:1 methanol/dichloromethane (~10 mg ml−1), and the extract was then evaporated to dryness and redissolved in 9:1 methanol/dichloromethane. The tanshinone content in the extract solution was determined by high-performance liquid chromatography on a HP1100 system using a C18 column, 55:45 acetonitrile/water as the mobile phase, and UV detection at 275 nm. The total tanshinone (TT) content shown in the results is the sum of three tanshinone species cryptotanshinone (CT), tanshinone-I (T1), and tanshinone-IIA (T2A), which were detected and quantified with authentic standards obtained from the Institute for Identification of Pharmaceutical and Biological Products (Beijing). The tanshinone content in the medium was negligible compared with that in the roots and not measured.
Hydrogen peroxide measurement
Hydrogen peroxide (H2O2) in the culture medium was measured by chemiluminescence through ferricyanide-catalyzed oxidation of luminol as described by Wang and Wu (2005). Briefly, 50-μl medium was added to 750 μl potassium phosphate buffer (0.05 M, pH 7.9). The luminescence was recorded after the last injection at an integration time of 5 s, and the luminescence intensity was calibrated to H2O2 concentration with pure H2O2 liquid (30 wt% in water from Junsei Chemical, Tokyo, Japan).
Results
Effects of live bacteria on hairy root growth and nutrient consumption
The B. cereus bacteria inoculated into the hairy root culture on day 0 had a negative effect on the root growth, decreasing the root dw (on day 28) from 7.07 g l−1 in the control culture to 4.25 g l−1 with 0.02% bacteria inoculum and to 3.90 g dw l−1 with 0.2% bacteria inoculum (Fig. 1a1). However, the bacteria inoculated to the root culture on day 14 (Fig. 1a2) or later (day 21, Table 1) did not cause any significant changes in the root growth (with the same root weight of 7.0–7.1 g dw l−1 on day 28). The bacteria inoculated to the hairy root culture on day 0 also resulted in a slower consumption of the major nutrients, as shown by the higher residual concentrations of sucrose (as the major carbon source; Fig. 1b1) and total nitrogen (Fig. 1c1), and a higher medium conductivity (attributed to metal ions and minerals) (Fig. 1d1). Similar to the effects of bacteria on the hairy root growth, the nutrient consumption rates were not significantly influenced by the inoculation of bacteria to the root cultures on day 14 (Fig. 1b2, c2, and d2) or later (e.g., day 21, Table 1). On the other hand, the inoculation of bacteria into the root cultures at any day (0, 14, or 21) caused a rapid and notable drop in the medium pH from 5.8 to about 4.0 (Fig. 1d). The addition of the bacterial suspension (pH 6.5) caused a slight increase (no more than 0.2 units) in the initial medium pH, and the bacteria cultured in the MS medium without roots caused a slight pH drop (no more than 0.3 units; data not shown).
Time courses of S. miltiorrhiza hairy root cultures inoculated with 0.02 and 0.2% B. cereus on days 0 (block 1) or 14 (block 2): a Root biomass growth or dry weight; b sucrose consumption (residual sucrose in culture medium); c nitrogen consumption (residual total Kjeldahl nitrogen in culture medium); d Medium pH and conductivity (error bars for standard deviation, n = 3)
Inhibition of bacteria growth by the hairy roots
In the shake flasks at 25°C, the B. cereus bacteria cultivated in the MS root culture medium without the roots had a specific growth rate (in the exponential phase) of 0.61 h−1 and a maximum cell density of 1.54 OD (on day 14), which were only slightly lower than those in the LB bacteria medium (Fig. 2a and Table 2, all based on OD measurement). The lower bacteria growth rate in the MS medium should be attributed mostly to its less favorable medium composition than the LB medium for bacteria growth. The bacteria growth rate was further suppressed in the MS medium cocultured with the hairy roots, with a specific growth rate of 0.57 h−1 (between 3 and 7 h) and a maximum cell density (OD) of 0.89 (on day 14). The difference between the bacterial cultures with and without the roots was even larger over the later days (days 3–14), during which the culture with the roots had only a small increase in the bacteria cell density (OD from 0.75 to 0.90), while that in the same medium but without the roots increased significantly (OD from 0.69 to 1.54; Fig. 2b). The results suggest that the hairy roots had an inhibitory effect on the bacteria growth, which became more significant as the amount of roots in the culture increased with time.
In addition to the above quantitative results, our observation during the experiments indicated that the bacteria growth or survival in the hairy root culture was very dependent on casein hydrolysate, a complex organic supplement that was routinely added to the medium at 0.5 g l−1. The root culture medium was fairly clear and transparent (low OD) when casein hydrolysate was excluded from the medium, suggesting that the bacteria did not grow well in the MS medium without casein hydrolysate.
Effects of live bacteria on tanshinone production of hairy roots
The hairy root culture receiving 0.02 and 0.2% bacteria inoculum on day 0, 14, or 21 all achieved a higher TT content in the roots than the bacteria-free control culture; the culture receiving a larger bacteria inoculum at an earlier day during the culture usually had a higher tanshinone content, i.e., day 0 > day 14 > day 21 (Fig. 3a, Table 1). The root culture inoculated with bacteria also attained a higher volumetric tanshinone yield (the product of root dw and TT content), although the final root dw was significantly lower than that of the control (3.90 vs 7.07 g dw l−1; Fig. 3b, Table 1). In this set of results, the culture inoculated with 0.2% bacteria on day 0 attained the highest tanshinone content of 2.67 mg g−1 dw and the highest volumetric yield of 10.4 mg l−1 (on day 28), which were 13.5- and 7.6-fold of those in the control, 0.20 mg g−1 dw and 1.40 mg l−1, respectively.
Effects of bacterial extract and culture supernatant on root growth and tanshinone production
The bacterial extract enhanced both the hairy root growth and tanshinone biosynthesis, more significantly when it was fed to the hairy root culture on day 0 than on day 21 (Table 1). With the bacterial extract fed on day 0, the root weight increased by nearly 50% (9.9 vs 6.78 g dw l−1 in the control), and the TT content of roots increased by about twofold, 0.54 vs 0.17 mg g−1 dw in control. Accordingly, the volumetric tanshinone yield was increased by about 3.5-fold.
The bacterial culture supernatant or used bacterial culture medium (in the absence of hairy roots) had a negligible effect on the root growth if the culture supernatant was collected from the bacterial culture on day 7 or earlier but had a positive effect when it was collected on day 21 (Fig. 4; Table 1). The stimulating effect of the older bacteria medium (on day 21 but not on day 7) was perhaps due to the release of root growth-stimulating compounds from the bacteria, which was consistent with the stimulating effect of the bacterial extract on the root growth. The root culture supernatant collected on day 21 caused a negative effect on the root growth probably because of the presence of waste metabolites. The bacterial culture and the root–bacteria coculture supernatants collected at any of the 3 days stimulated the tanshinone accumulation in the hairy roots, most significantly with the root–bacteria coculture supernatant collected on day 21, increasing the tanshinone content of roots by nearly fourfold from 0.16 to 0.79 mg g−1 dw.
Figure 5 shows the contents of three individual tanshinone species CT, T1, and T2A in the roots, which were all stimulated by the three bacterial treatments, live bacteria, bacterial extract, and bacterial culture medium. There was a notable difference in the extents of stimulation of the different tanshinone species by these treatments.
Contents of three major tanshinones, cryptotanshinone (CT), tanshinone-I (T1), and tanshinone-IIA (T2A) in the hairy roots treated with various bacterial culture components: 0.2% B. 0.2% live bacteria, B.E. 100 mg l−1 bacteria cell extract, B.med. bacterial culture supernatant collected at 24 h, B.-R. med. root–bacteria coculture supernatant collected on day 21 (all fed to the hairy root cultures on day 0; error bars for SD, n = 3)
H2O2 production induced by live bacteria in hairy root cultures
As shown in Fig. 6, the inoculation of 0.2% bacteria into the hairy root cultures induced a sharp and rapid increase in the hydrogen peroxide (H2O2) level, reaching a peak of about 100 times over the initial and control level within 1.5 h after inoculation. The inoculation of bacteria at a lower concentration of 0.02% (v/v) also induced a rapid but smaller increase in the H2O2 level, to a peak of about 6.8 times higher than the initial and control level in 1 h. At both bacteria concentrations, the bacteria-induced H2O2 increase in the hairy root cultures could be detected within 10 min of inoculation. The results show that the bacteria inoculation induced a rapid and transient production of H2O2 in the hairy root cultures, and the production level was bacteria concentration dependent. Likewise, the increase in H2O2 production also occurred in the root cultures treated with the bacterial extract and culture media (data not shown).
Discussion
The above experimental results clearly show that the coculture of S. miltiorrhiza hairy roots with the Bacillus bacteria can enhance the accumulation of diterpenoid tanshinones in the hairy roots. Although the presence of live bacteria in the hairy root culture also caused an inhibition of the hairy root growth, the stimulation of secondary metabolite accumulation was much more substantial, thus leading to a significant net increase in the volumetric yield of tanshinones. On the other hand, the bacteria growth in the hairy root culture was also inhibited by the hairy roots, perhaps because of the antimicrobial effects of compounds produced by the roots. It has been reported that some of the tanshinones in Danshen, such as CT and dihydrotanshinone-I, have a strong antibacterial activity on a broad range of Gram-positive bacteria including two strains of Bacillus subtilis, although they are less active against Gram-negative bacteria (Lee et al. 1999). The antibacterial compounds released to the medium (although at very low concentrations) may contribute to the prevention of proliferation of B. cereus (also a Gram-positive species) in the S. miltiorrhiza hairy root culture, allowing for the continued growth and proliferation of the roots for many passages in the presence of bacteria. The more pronounced inhibition of bacteria growth in the later culture period (Fig. 2a) may be due partially to the accumulation of antibacterial compounds in the culture medium. Moreover, the significantly lower medium pH in the root–bacteria coculture than the optimal pH 6.5–7.0 (in the LB medium) for the bacteria growth could also contribute to the bacteria growth inhibition.
The most possible cause for the enhanced tanshinone production in the hairy root–bacteria coculture is the action of some elicitor compounds generated and released by the B. cereus bacteria. The rapid and transient production of ROS H2O2 in the hairy root cultures induced by the bacteria (Fig. 6) is a characteristic response of plants to elicitors (Ebel and Cosio 1994; Zhao et al. 2005). This deduction is further supported by the stimulating effects of the bacteria cell extract and the used bacterial culture medium as shown in our experiments. Because the bacterial culture and the root–bacteria coculture supernatants had a similar stimulating effect on the tanshinone production, these elicitor compounds should mainly be the constituents or the extracellular products of bacteria cells instead of the products of root–bacteria interaction. The much stronger stimulation by the live bacteria than the bacterial extract and the bacterial culture supernatant may be due to that the live bacteria’s provision of a source of fresh and active elicitors or stimulants for the secondary metabolite biosynthesis. Another possible cause for the enhanced tanshinone production in the root–bacteria coculture is the stress conditions imposed by the bacteria to the roots, such as the medium pH drop, which may stimulate the secondary metabolite biosynthesis of roots. However, the stress because of the competition for nutrients or nutrient deficiency can be ruled out as a significant factor because the consumption rates of nutrients including sugar, nitrogen, and metal and minerals did not show any increase after the bacteria inoculation. In this connection, the nutrients should be utilized mainly by the roots but not by the bacteria. The very low maximum cell density as well as the low growth rate of bacteria in the hairy root culture (Fig. 1 and Table 2) also imply that the bacteria cells did not consume much of the major growth nutrients available in the culture medium.
The pH drop after bacteria inoculation (Fig. 2d) was most probably caused by the extrusion of protons H+ from plant cells (by the action of plasma membrane H+-ATPase) and/or the production of acidic metabolites by the bacteria cells. Similar to our results, a pH drop was also observed in bacteria-challenged tobacco cell culture within a few hours of postbacteria inoculation (Able et al. 2001). This seems to be in contrast to the medium alkalinization resulting from the H+ influx/K+ efflux exchange, which commonly occurs in plant tissue cultures after elicitor treatment (Atkinson et al. 1985, 1990; Keppler et al. 1989; Zhao et al. 2005). It has been suggested that the acidification or alkalinization of the extracellular medium is dependant on the difference between the race-specific and nonspecific microbial elicitors (De Wit 1995). Moreover, transient cytoplasmic acidification has been detected concomitantly with the extracellular alkalinization and regarded as a necessary step in signaling the elicitor-induced secondary metabolite biosynthesis in plant cells (Roos et al. 1998; Sakano 2001).
In conclusion, the inoculation of a Bacillus bacterium into the S. miltiorrhiza hairy root culture dramatically enhanced the tanshinone production of roots. The enhanced secondary metabolite accumulation in the roots may be a defense response of the hairy roots induced by some elicitor compounds released from the bacteria cells living in the root cultures. Compared with the chemical elicitors, however, the live bacteria may have different and more complex interactions with the roots such as cell–cell, gene–gene, and protein–protein interactions, and their involvement in the root–bacteria coculture process remains to be investigated. To the best of our knowledge, this is the first report on plant tissue growth and secondary metabolite production in plant tissue–microbe coculture system and on the stimulation of secondary metabolite biosynthesis in plant tissue cultures by live microbial cells. The hairy root–bacteria coculture used in this study may present a novel and effective strategy for improving the production of valuable secondary metabolites in plant tissue cultures as well as a convenient experimental system for the study of plant–microbe interactions.
References
Able AJ, Guest DI, Sutherland MW (2001) Relationship between transmembrane ion movements, production of reactive oxygen species and the hypersensitive response during the challenge of tobacco suspension cells by zoospores of Phytophthora nicotianae. Physiol Mol Plant Pathol 58:189–198
Able AJ, Sutherland MW, Guest DI (2003) Production of reactive oxygen species during non-specific elicitation, non-host resistance and field resistance expression in cultured tobacco cells. Funct Plant Biol 30:91–99
Atkinson MM, Huang JS, Knopp JA (1985) The hypersensitive reaction of tobacco to . Pseudomonas syringae pv. pisi. Plant Physiol 79:843–847
Atkinson MM, Keppler LD, Orlandi EW, Baker CJ, Mischke CF (1990) Involvement of plasma membrane calcium influx in bacterial induction of the K+/H+ and hypersensitive responses in tobacco. Plant Physiol 92:215–221
Barea JM, Pozo MJ, Azcón R, Azcón-Aguilar C (2005) Microbial co-operation in the rhizosphere. J Exp Bot 56:1761–1778
Chen H, Chen F, Zhang YL, Song JY (1999) Production of lithospermic acid B and rosmarinic acid in hairy root cultures of Salvia miltiorrhiza. J Ind Microbiol Biotechnol 22:133–138
Chen H, Chen F, Chiu FCK, Lo CMY (2001) The effect of yeast elicitor on the growth and secondary metabolism of hairy root cultures of Salvia miltiorrhiza. Enzyme Microbial Technol 28:100–105
De Wit PJGM (1995) Fungal avirulence genes and plant resistance genes: unravelling the molecular basis of gene for gene interactions. Adv Bot Res 21:148–177
Ebell LF (1969) Variation in total soluble sugars of conifer tissues with method of analysis. Phytochemistry 8:227–233
Ebel J, Cosio EG (1994) Elicitors of plant defense responses. Int Rev Cytol 148:1–36
Ge X, Wu J (2005) Tanshinone production and isoprenoid pathways in Salvia miltiorrhiza hairy roots induced by Ag+ and yeast elicitor. Plant Sci 168:487–491
Giri A, Narasu L (2000) Transformed hairy roots: recent trends and applications. Biotechnol Adv 18:1–22
Guillon S, Trémouillaux-Guiller J, Pati PK, Rideau M, Gantet P (2006) Hairy root research: recent scenario and exciting prospects. Curr Op Plant Biol 9:341–346
Hu ZB, Alfermann AW (1993) Diterpenoid production in hairy root cultures of Salvia miltiorrhiza. Phytochemistry 32:699–703
Keppler LD, Baker CJ, Atkinson MM (1989) Active oxygen production during a bacteria-induced hypersensitive reaction in tobacco suspension cells. Phytopathology 79:974–978
Kloepper JW, Ryu CM, Zhang SA (2004) Induced systemic resistance and promotion of plant growth by Bacillus spp. Phytopathology 94:1259–1266
Lee DS, Lee SH, Noh JG, Hong SD (1999) Antibacterial activities of cryptotanshinone and dihydrotanshinone I from a medicinal herb, Salvia miltiorrhiza Bunge. Biosci Biotechnol Biochem 63:2236–2239
Murashige T, Skoog FA (1962) A revised medium for rapid growth and biosynthesis with tobacco tissue cultures. Physiol Plant 15:473–497
Rao SR, Ravishankar GA (2002) Plant cell cultures: Chemical factories of secondary metabolites. Biotechnol Adv 20:101–153
Roos W, Evers S, Hieke M, Tschöpe M, Schumann B (1998) Shifts of intracellular pH distribution as a part of the signal mechanism leading to the elicitation of benzophenan thridine alkaloids. Plant Physiol 118:349–364
Sakano K (2001) Metabolic regulation of pH in plant cells: role of cytoplasmic pH in defense reaction and secondary metabolism. Int Rev Cytol 206:1–44
Tang W, Eisenbrand G (1992) Chinese drugs of plant origin: chemistry, pharmacology, and use in traditional and modern medicine. Springer, Berlin, pp 891–902
Wang JW, Wu JY (2005) Nitric oxide is involved in methyl jasmonate-induced defense responses and secondary metabolism activities of Taxus cells. Plant Cell Physiol 46:923–930
Wang X, Morris-Natschke SL, Lee KH (2007) New developments in the chemistry and biology of the bioactive constituents of Tanshen. Med Res Rev 27:133–148
Zhao J, Davis LC, Verpoorte R (2005) Elicitor signal transduction leading to production of plant secondary metabolites. Biotechnol Adv 23:283–333
Acknowledgments
This work was supported by grants (G-U150 and A-PE94) from The Hong Kong Polytechnic University.
Author information
Authors and Affiliations
Corresponding author
Rights and permissions
About this article
Cite this article
Wu, JY., Ng, J., Shi, M. et al. Enhanced secondary metabolite (tanshinone) production of Salvia miltiorrhiza hairy roots in a novel root–bacteria coculture process. Appl Microbiol Biotechnol 77, 543–550 (2007). https://doi.org/10.1007/s00253-007-1192-5
Received:
Revised:
Accepted:
Published:
Issue Date:
DOI: https://doi.org/10.1007/s00253-007-1192-5